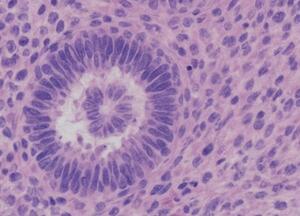

Introduction
Anti-NMDA receptor encephalitis is an autoimmune disorder caused by antibodies against the GluN1 subunit of NMDA receptors in the central nervous system, which results in synaptic transmission disruption and neuropsychiatric manifestations.1 The disease primarily affects young women and is usually associated with ovarian teratomas, although idiopathic and post-infectious cases were reported.2 Initial symptoms often include behavioral changes, psychosis, hallucinations, and cognitive deficits, which may lead to the initial misdiagnosis of a primary psychiatric disorder.3 Neurological symptoms such as seizures, dyskinesias, autonomic dysfunction, and decreased level of consciousness typically appear within days to weeks.4
Early diagnosis is crucial, as early tumor removal and immunotherapy carry a favorable prognosis, whereas delayed treatment can lead to long-term morbidity,5 which may manifest in the form of prolonged ICU admission, mechanical ventilation, and persistent cognitive deficits.6 Diagnosis relies on the combination of clinical evaluation, CSF and serum antibody detection, electroencephalography (EEG), and imaging studies7; however, MRI imaging may be normal in early stages, which adds to the disease’s diagnostic difficulty.8 We present a detailed case of anti-NMDA receptor encephalitis initially misdiagnosed as a primary psychiatric illness, highlighting the importance of maintaining high suspicion for autoimmune encephalitis in patients presenting with acute and atypical psychiatric and neurological symptoms.
Case Presentation
A 24-year-old female with no prior psychiatric or neurological history presented to the emergency department with a sudden onset of agitation, auditory hallucinations, and paranoid delusions. Blood pressure ranged from 150/90 to 90/60 mmHg, heart rate was 125 bpm, respiratory rate was 10–14/min with intermittent hypoventilation, SpO₂ was 94% on room air, and temperature was 37.4°C. According to her family, she had been exhibiting unusual behavior for one week prior, including insomnia, emotional lability, and irritability. She was initially admitted to a psychiatric unit and started on antipsychotic therapy for the management of acute psychosis; however, her symptoms rapidly worsened. Within three days, neurological deterioration occurred, including generalized tonic-clonic seizures and intermittent orofacial dyskinesias. Examination revealed limb rigidity, dystonia, and autonomic instability—manifested as tachycardia, labile blood pressure, and intermittent hypoventilation—along with fluctuating consciousness, preserved sensory function, and normal deep tendon reflexes.
Routine laboratory workup showed mild leukocytosis (white blood cell count: 12,000 cells/µL), with normal serum electrolytes, liver, and renal function tests. Cerebrospinal fluid (CSF) analysis revealed a protein level of 40 mg/dL, glucose of 65 mg/dL, and a white blood cell count of 12 cells/µL (reference: 0-5). Importantly, CSF anti-NMDA receptor antibodies were strongly positive (1:320), whereas serum antibodies were borderline positive (1:40) (Table 1).
Electroencephalogram (EEG) demonstrated diffuse slowing with intermittent delta brush patterns, consistent with autoimmune encephalitis. The brain MRI was unremarkable, a finding commonly seen in early-stage disease (Figure 1).
Due to suspicion of paraneoplastic autoimmune encephalitis, a pelvic ultrasound was performed, revealing a 3-cm left ovarian mass suggestive of a teratoma. Laparoscopic excision confirmed a mature cystic teratoma containing neural tissue elements (Figure 2). Postoperatively, immunotherapy with intravenous methylprednisolone (1 g/day for five days) and intravenous immunoglobulin (0.4 g/kg/day for five days) was initiated. Antipsychotics were gradually tapered as neurological recovery ensued.
Over the following month, the patient showed gradual neurological improvement. Seizures resolved completely, movement disorders decreased, and autonomic instability normalized. Psychiatric manifestations, including hallucinations and agitation, remitted within six weeks, and cognitive function gradually returned to baseline. Repeat CSF testing at three months demonstrated declining antibody titers, which correlated with clinical recovery. At six months, she had fully reintegrated into daily life, without any residual neurological or psychiatric deficits.
Discussion
Anti-NMDA receptor encephalitis is increasingly recognized as a leading cause of autoimmune encephalitis in young adults. The disease mechanism involves antibodies against GluN1 subunits, causing NMDA receptor internalization and impaired excitatory neurotransmission in cortical and limbic regions.9 Psychiatric manifestations dominate the early clinical course, often resulting in initial misdiagnosis as a primary psychiatric illness in up to 77% of patients.10 Recognition of atypical neurological signs such as seizures, movement disorders, or autonomic instability should prompt evaluation for autoimmune encephalitis.
CSF antibody detection remains the most sensitive diagnostic test. EEG and MRI may support diagnosis but can be nonspecific or normal, particularly early in disease, emphasizing the importance of clinical suspicion.11 Tumor association, particularly ovarian teratoma in young females, is common, and early tumor resection significantly improves recovery and reduces antibody titers.12 First-line immunotherapy with corticosteroids, intravenous immunoglobulin, and plasma exchange is effective, while second-line agents such as rituximab or cyclophosphamide are reserved for refractory cases.13
In our case, early recognition, CSF testing, tumor resection, and immunotherapy resulted in near-complete neurological recovery, highlighting the importance of multidisciplinary management. Delayed diagnosis may lead to prolonged hospitalization, ICU admission, and residual cognitive deficits.14 Previous studies report functional recovery in 75–80% of patients within six to twelve months when early intervention is initiated.15 Limitations include the single-case design and lack of long-term antibody titer monitoring beyond one year. Nonetheless, this case reinforces the importance of early detection and comprehensive management in anti-NMDA receptor encephalitis.
Conclusion
Anti-NMDA receptor encephalitis can mimic primary psychiatric disorders, particularly in young adults. Early clinical suspicion, CSF antibody testing, EEG, and tumor screening are essential for timely immunotherapy and surgical intervention. Multidisciplinary management significantly improves neurological outcomes and functional recovery. This case underscores the importance of integrating clinical, serological, and imaging findings to avoid misdiagnosis and optimize patient care.
Ethical Consideration
Written informed consent was obtained from the patient for publication of this case report and accompanying images. IRB approval was not required for this single-patient case report, as per institutional policy.